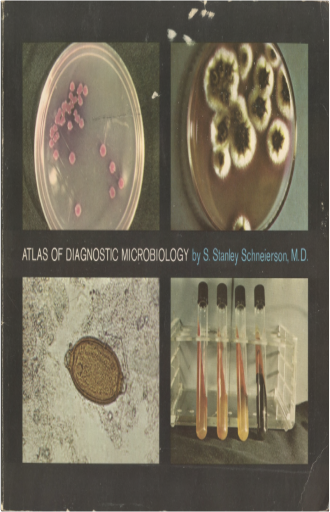

![]() In the early days of photography, many believed and hoped that the camera would prove more efficient than the human eye in capturing the unseen. Spiritualists and animists of the nineteenth century seized on the new technology as a method of substantiating the existence of supernatural beings and happenings. This fascinating book assembles more than 250 photographic images from the Victorian era to the 1960s, each purporting to document an occult phenomenon: levitations, apparitions, transfigurations, ectoplasms, spectres, ghosts, and auras. Drawn from the archives of European and American occult societies and private and public collections, the photographs in many cases have never before been published. ![]() 3981022009 ![]() 394164422X ![]() This illustrated colour guide shows dentists how to identify dental diseases of all kinds. ![]() THE PRESIDENT'S VAMPIRE is proof positive that an inordinate number of very strange things happen from sea to shining sea in the place known as the United States of America. It contains scrupulously documented accounts of ghosts, monsters, murderers, and hoaxes so improbable they will fascinate believers, skeptics, and anyone interested in the more obscure corners of American history and culture. "Robert Schneck is one of the best of a new breed of investigators into the relatively unknown byways of our cultural history. Because he is thoroughly familiar with his subject, writes with deceptive ease and a clarity that both amuses and educates, and because he never forgets that at the heart of even the strangest or most frightening of mysteries there are real human beings with a story to tell, I recommend him as a trusted guide." - Bob Rickard, Fortean Times Robert Damon Schneck is a freelance writer and contributor to Fortean Times, Fate, and other magazines. Friends describe him as a "loveable, nocturnal, monomaniac." | ![]() Portraits of the Mind follows the fascinating history of our exploration of the brain through images, from medieval sketches and 19th-century drawings by the founder of modern neuroscience to images produced using state-of-the-art techniques, allowing us to see the fantastic networks in the brain as never before. These black-and-white and vibrantly colored images, many resembling abstract art, are employed daily by scientists around the world, but most have never before been seen by the general public. Each chapter addresses a different set of techniques for studying the brain as revealed through the images, and each is introduced by a leading scientist in that field of study. Author Carl Schoonover’s captions provide detailed explanations of each image as well as the major insights gained by scientists over the course of the past 20 years. Accessible to a wide audience, this book reveals the elegant methods applied to study the mind, giving readers a peek at its innermost workings, helping us to understand them, and offering clues about what may lie ahead. ![]() This volume launches a new, eight-volume series entitled Theatrum Scientiarum on the history of science and the media which has arisen from the work of the Berlin special research project on "Performative Cultures" under the aegis of the Theatre Studies Department of the Free University. The volume examines the role of space in the constitution of knowledge in the early modern age. "Kunstkammern" (art and curiosities cabinets), laboratories and stages arose in the 17th century as instruments of research and representation. There is, however, still a lack of precise descriptions of the epistemic contribution made by material and immaterial space in the performance of knowledge. Therefore, the authors present a novel view of the conditions surrounding the creation of these spatial forms. Account is taken both of the institutional framework of these spaces and their placement within the history of ideas, the architectural models and the modular differentiations, and the scientific consequences of particular design decisions. Manifold paths are followed between the location of the observer in the representational space of science and the organization in time and space of sight, speech and action in the canon of European theatrical forms. Not only is an account given of the mutual architectural and intellectual influence of the spaces of knowledge and the performance spaces of art; they are also analyzed to ascertain what was possible in them and through them. This volume is the English translation of Kunstkammer, Laboratorium, Bühne (de Gruyter, Berlin, 2003). ![]() This textbook, which outlines the pathophysiology and treatment options of surgical diseases, is currently in its sixth edition. The authors present surgical knowledge based on normal and abnormal physiology, thereby making treatment for various diseases easily understandable and logical. The stated audience includes medical students, surgeons-in-training, and practicing physicians. Although medical students may find this book too detailed and long for use during a surgical clerkship, it is most valuable to surgical residents who need a broad understanding of disease states and treatments. It is also an excellent review for practicing surgeons. The book is organized into "Basic Considerations" and "Specific Considerations. ![]() During the second half of the nineteenth century, Paris emerged as the entertainment capital of the world. The sparkling redesigned city fostered a culture of energetic crowd-pleasing and multi-sensory amusements that would apprehend and represent real life as spectacle. |

Made with Delicious Library